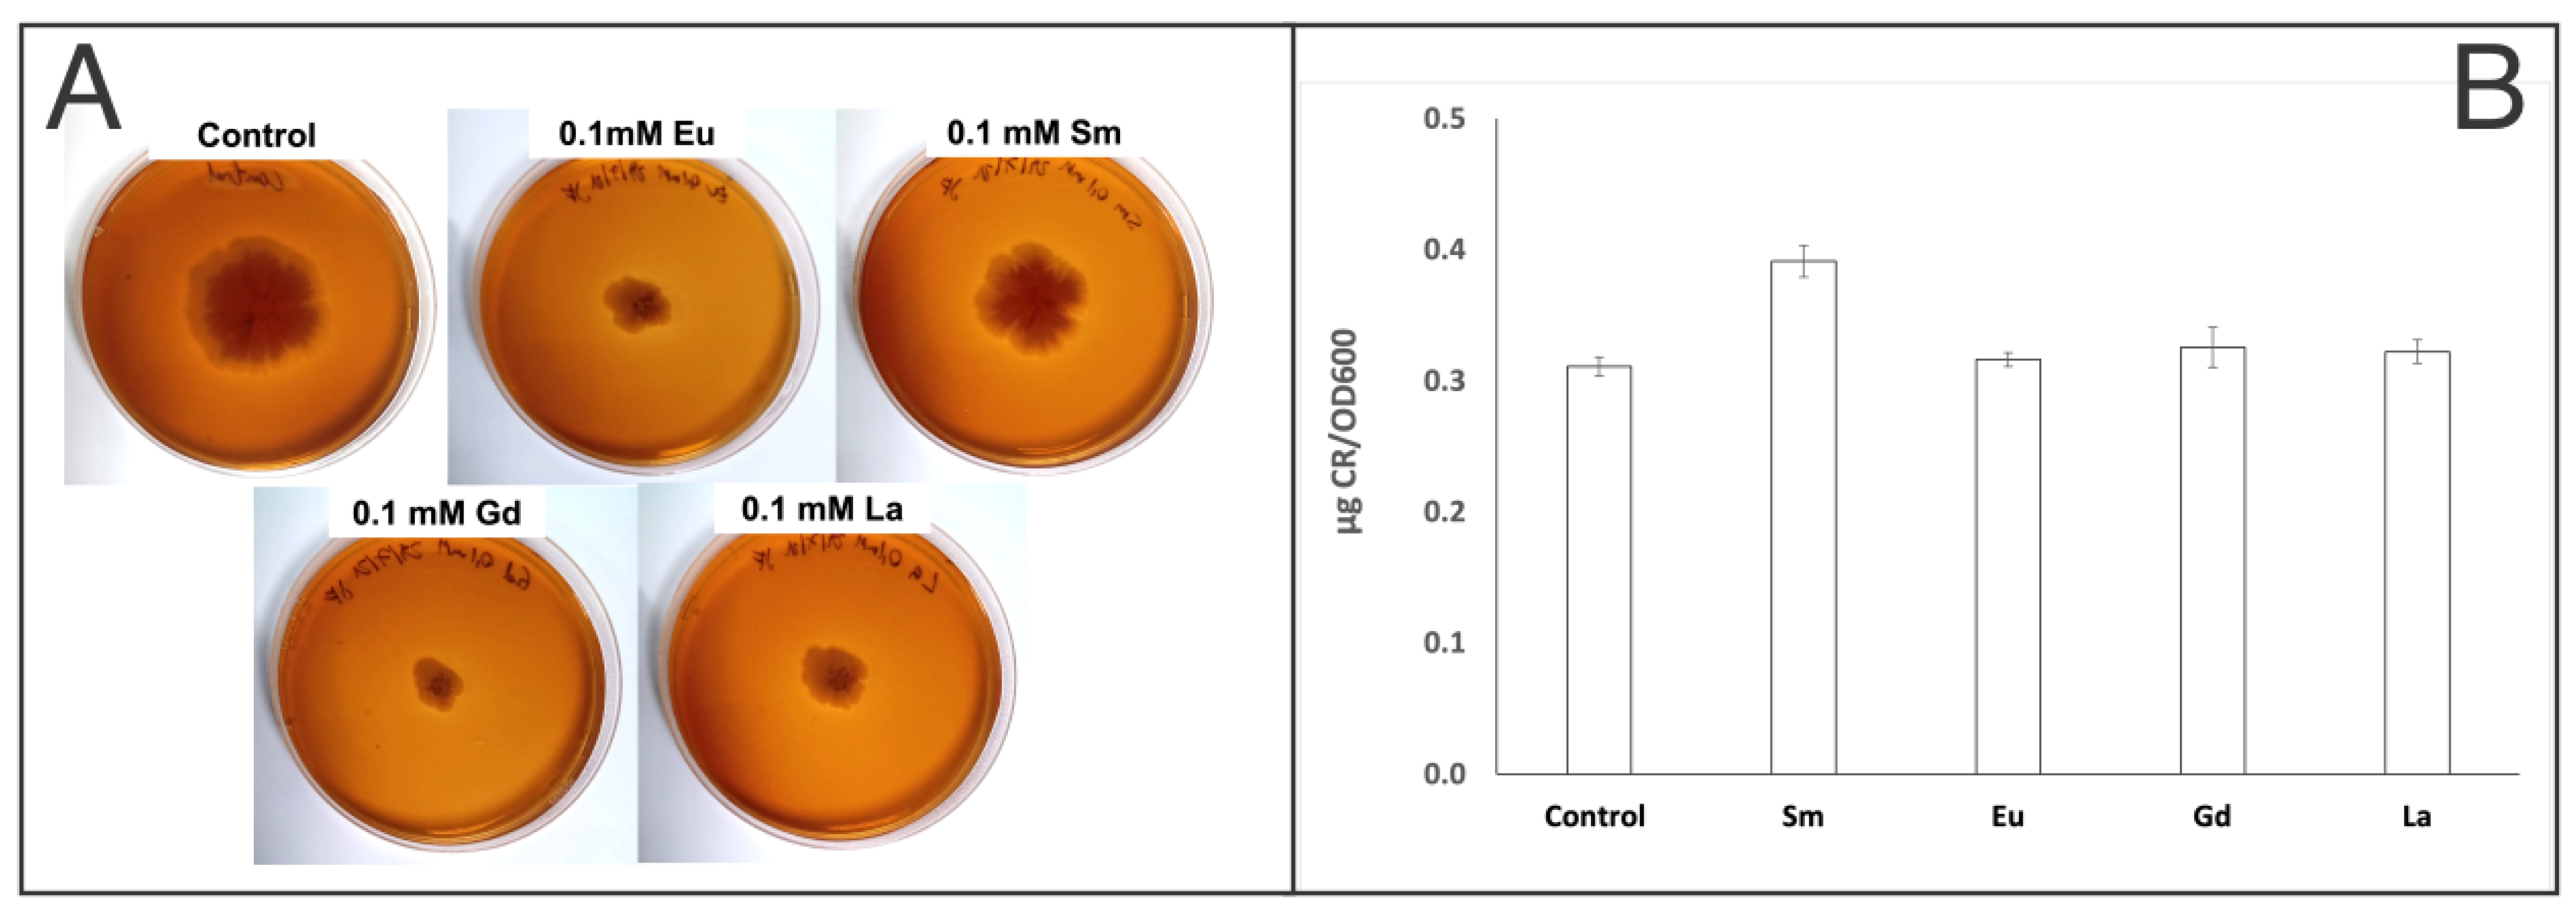
Processes 12 00047 g002

1. Introduction
Rare-earth elements (REEs) are a group that consists of seventeen elements, which can be divided into light rare-earth elements (LREEs) and heavy rare-earth elements (HREEs). Rare-earth elements include lanthanum (La), cerium (Ce), praseodymium (Pr), neodymium (Nd), promethium (Pm), samarium (Sm), europium (Eu), gadolinium (Gd), terbium (Tb), dysprosium (Dy), holmium (Ho), erbium (Er), thulium (Tm), ytterbium (Yb), lutetium (Lu), as well as yttrium (Y) and scandium (Sc) [
1,
2]. Due to the properties of these metals, such as chemical, electrical, optical, and catalytic properties, rare-earth elements play an essential role in high-tech materials, renewable energy developments, materials for lighter flints, fluorescent lamps, high-temperature superconductivity, information storage, energy conservation, and transportation [
2]. Given the growing demand for rare-earth elements, it is essential to explore new and sustainable technologies for recovering these metals from secondary sources. Separating rare-earth elements is challenging, due to their similar chemical properties, because the outermost electron shell is filled the same way, causing these elements to react in similar ways [
3]. As a result, several methods have been explored, including adsorption, liquid–liquid extraction, chemical precipitation, and ion exchange. The main issue with these protocols, especially when considering large-scale implementation, is the consumption of significant quantities of toxic chemicals and solvents (such as organic solvents and acids, among others), leading to the generation of substantial amounts of waste residues [
4,
5]. For this reason, biosorption is considered a potential and sustainable technique for metal recovery, as it has been shown to be efficient in recovering various elements, including rare-earth elements [
6,
7,
8,
9]. Moreover, it has been reported that biosorption by microbial cells is more effective compared to physico-chemical adsorbents [
10,
11]. This enhancement is influenced by several biochemical processes, such as enzymatic oxidation and reduction, and passive sequestration of metal ions on their cell wall surfaces. Considering the large surface area of the cells, metals can be coordinated by functional groups such as phosphoryl and/or carboxyl, facilitating a high biosorption capacity for rare-earth elements [
12,
13]. Carboxyl groups are mainly responsible for coordinating heavy rare-earth elements, while phosphoryl groups coordinate light rare-earth elements [
14]. For instance, extracellular polymeric substances are different classes of organic macromolecules located outside of cells or within microbial aggregates [
15]. Extracellular polymeric substances are composed mainly of polysaccharides and proteins but also include humic acids, nucleic acids, lipids, and uronic acids. Therefore, these macromolecules are capable of interacting with cationic species in solution, representing potential metal-binding sites. For example, extracellular polymeric substances from bacterial strains such as
Pseudomonas,
Halomonas,
Paenibacillus,
Bacillus, and
Herbaspirillum can remove more than 50% of heavy metals, such as Pb
2+ and Hg
2+, irrespective of the bacterial strain. Cd
2+ removal can be enhanced by increasing the concentration of extracellular polymeric substances up to 10,000 mg/L at 45 °C. Moreover, extracellular polymeric substances from
Bacillus subtilis removed heavy metals such as Zn
2+, Pb
2+, and Cu
2+ [
16]. Previous reports have shown that
Exiguobacterium strains are capable of producing extracellular polymeric substances, and the concentration depends on pH and growth temperature [
17,
18]. Furthermore, this microorganism has the characteristic of tolerating high NaCl and As concentrations [
19,
20]. This makes it interesting to explore new potential applications. Given that this microorganism is the model strain of our research group [
19,
20], which was previously isolated from Salar de Huasco [
19], the aim of this work was to evaluate the tolerance and biosorption efficiency of
Exiguobacterium sp. SH31 towards 0.1 and 1 mM aqueous solutions of Eu
3+, Sm
3+, Gd
3+, and La
3+ at different pHpzc values. Changes in extracellular polymeric substance production were investigated, as well as the functional groups present in the cell wall, and the explored genes were related to the formation and maintenance of extracellular polymeric substances.
2. Materials and Methods
Growth curves: The growth kinetics of the SH31 strain under 0.1 and 1 mM concentrations of the different rare-earth elements in Luria–Bertani (LB) medium at pHpzc 7, 7.5, and 8 were monitored for 24 h at 37 °C with continuous orbital agitation (150 rpm), and 1% bacterial inoculum. Metals were introduced when the bacteria entered the exponential phase, and growth curves were subsequently monitored over a 24 h period. Optical density at 600 nm (OD600) measures was recorded every hour using a microplate reader (Infinite® 200 Pro, Tecan, Männedorf, Switzerland). The control condition was prepared in the same manner but without the addition of any rare-earth element; negative control corresponds to the same conditions minus the addition of bacterial inoculum. Each assayed condition was performed in three independent experiments with three technical replicates each, and visualizations were performed with GraphPad Prism v6.
Extracellular polymeric substances presence and quantification: Extracellular polymeric substance production was assessed by inoculating the
Exiguobacterium strain on Congo red agar (CRA), as previously reported with some modifications [
21,
22]. Amounts of 10 g/L tryptone, 5 g/L yeast extract, 1% agar, 40 µg/mL Congo red, 20 µg/mL Coomassie brilliant blue, and an aqueous solution of rare-earth elements (independently added at a concentration of 0.1 mM to each one), were used for CRA plates. About 50 mL of
Exiguobacterium sp. grown (at stationary phase) was streaked onto the center of the agar plates. Then, samples were incubated at 30 °C for seven days with daily checking [
21,
22].
Quantification of extracellular polymeric substance production was performed as previously reported with modifications [
21,
23]. An amount of 3 mL of growth cultures was centrifuged for 5 min at 9000 rpm×
g. The supernatant was removed and cells were resuspended in 1 mL of culture media containing Congo red (40 μg/mL). Samples were shaken at 250 rpm at room temperature for 90 min, followed by centrifugation for 5 min at 9000 rpm×
g. Finally, the supernatant was quantified using the UV–vis spectrophotometric technique (Shimadzu 1800) at OD490nm and compared with a calibration curve using appropriate Congo red standards (from 5 to 100 μg/mL) in LB medium to obtain the desired concentration [
21]. Three independent replicates were analyzed for extracellular polymeric substance quantification. The obtained data were analyzed using a one-way ANOVA test from R project software (R Core Team (2022);
https://www.R-project.org/). Tukey’s post hoc comparison was used when significant differences (
p < 0.05) were found in each analysis.
Analytical performance of ICP-OES for rare-earth element quantification: The analytical performance of ICP-OES for rare-earth element quantification in microbial cultures was evaluated. The calibration curve for all four rare-earth elements was generated from 0.1 to 5 mg/L, and a higher linearity of >0.99 was obtained. Limits of detection and quantification (LOD and LOQ) were calculated as 3.3 σ/slope and 10 σ/slope, respectively [
24]. LOD and LOQ were determined to be 3.95 and 12 µg/L for La, 25.1 and 76 µg/L for Sm, 12.1 and 36.7 µg/L for Eu, and 11.3 and 34.1 µg/L for Gd, respectively.
Metal sorption assays: A multielement calibration curve for quantification was performed using a Perkin Elmer Optima 7000DV model for inductively coupled plasma optical emission spectrometry (ICP-OES). Metal standard concentrations ranged from 0.1 to 5 mg/L. Three analytical replicates were measured in order to obtain the standard deviation of the calibration curve. The wavelengths used for every metal were 398.852 nm for La, 359.260 nm for Sm, 381.967 nm for Eu, and 342.247 nm for Gd. Samples for metal adsorption analysis were used when microorganisms were in the stationary phase. Cultures were centrifugated at 10,000 rpm×
g and the supernatants were filtered using 0.45 µm MCE (mixed cellulose esters) filters, while the cellular pellet was stored for Fourier transform infrared spectroscopy–attenuated total reflectance (ATR-FTIR) analysis. Filtered samples were stored and quantified by ICP-OES in triplicates. The metal removal efficiency (Ad%) and adsorption capacity (qe) at different pHpzc values were calculated using the following equations:
where
Ad% is the metal removal efficiency and
qe is the adsorption capacity.
Ci and
Ce are the initial metal and residual concentrations, respectively.
V is the volume of the aqueous solution and
m is the mass of the cellular pellet used. Considering the adsorption capacity, adsorption isotherms for every rare-earth element were described at pHpzc values of 7, 7.5, and 8. Isotherm models are represented in Equations (3)–(5) for Freundlich, Langmuir, and Temkin, respectively, as shown in
Table 1.
Fourier transform infrared spectroscopy–attenuated total reflectance (ATR-FTIR) characterization: To study the surface chemistry, as functional group changes in the SH31 strain before and after adsorption of rare-earth elements, attenuated total reflection (ATR) was used as a sampling technique alongside traditional infrared spectroscopy Fourier transform infrared (FTIR). ATR-FTIR analysis (Perkin Elmer Spectrum 100 spectrometer) was used for identifying the functional groups on the bacterial surface. Bare pellet cellular and microorganisms containing rare-earth elements were loaded on the ATR and analyzed directly for their active functional groups in the wavenumber region of 700 to 4000 cm−1.
Functional potential evaluation: Bi-directional best-hit searches using CRB-BLAST v0.6.6 [
25] were performed (e-value ≤ 1 × 10
−5, identity ≥ 70%, and query coverage ≥ 70%) using the predicted proteins of the SH31 genome (GenBank: ASM181610v1 [
20]) as queries against custom-made protein databases with sequences related to our interest functions (siderophores, extracellular polymeric substance production, and lanthanide metabolism/resistance/tolerance) in the GenBank—Identical Protein groups. Functions of the identified proteins were evaluated in the UniProt database [
26] and using the InterProScan [
27] and String v11.0 tools [
28].
3. Results
Effect of Rare-earth elements in the growth of
Exiguobacterium sp. SH31: Initially, we assessed the tolerance of the SH31 strain to several rare-earth elements, such as Eu
3+, La
3+, Sm
3+, and Gd
3+, and at different pHpzc values. The chosen pH range was determined based on the observed inability of the SH31 strain to thrive at lower pH levels. Additionally, higher pH values (pH > 8) were not investigated, as there was a concern about the potential precipitation of rare-earth elements [
29]. Growth curves showed no major changes at the exponential phase (from 2 to 6 h approximately) between positive control and cultures grown in the presence of metals. However, it was observed that Eu- and Sm-containing cultures have similar performance in the stationary phase and maximum optical density achieved (OD
600 value about 0.5). On the other hand, La- and Gd-containing cultures in addition to positive control reached slightly higher optical density (closer to 0.6 OD600nm) as shown in
Figure 1.
Additionally, growth curves at pHpzc 7.5 and 8 were generated, which can be checked in
Figure S1, respectively. Results at pHpzc 7.5 are very similar to those at pHpzc 7 since the OD600 value reached about 0.6. For pHpzc 8, the growth curve reached higher OD600 values, but the exponential phase initiated later than in pHpzc 7 and 7.5. Moreover, growth curves at higher rare-earth element concentrations were generated (1 mM) showing a positive growth behavior (
Figure S2).
Effect of rare-earth elements in the extracellular polymeric substance production of
Exiguobacterium sp. SH31: in order to verify whether the SH31 strain produces extracellular polymeric substances, a Congo red (CR) assay in plates was performed. The results indicated that the SH31 strain has the capacity to produce extracellular polymeric substances, under the studied conditions (as shown in
Figure 2A). Although visual changes could be observed in agar plate assays, indirect quantitative analysis was performed to determine changes in the extracellular polymeric substance production. CR-binding quantification by UV–vis spectroscopy was expressed as µg CR/OD
600, and the results showed no significant changes in the presence of Eu, Gd, and La compared to a sample that did not contain a rare-earth element, according to ANOVA and Tukey’s test on R (
Table S1). It means that extracellular polymeric substances are produced in the presence of Eu, Gd, and La, and therefore metal sorption might occur. On the other hand, in the presence of Sm, extracellular polymeric substance production increased according to CR-binding quantification (
Figure 2B and
Table S2), and according to statistical analysis, this is the only condition that changes significantly compared to previous samples. This is the first report showing the effect of some rare-earth elements in the extracellular polymeric substance production of the SH31 strain.
Sorption capacity of
Exiguobacterium sp. SH31: Determination of sorption capacities of microbial cultures in the stationary phase was performed. Since growth curves showed that the SH31 strain did not tolerate lower pHpzc (<7), the sorption capacity was studied as a function of pHpzc, considering values of 7, 7.5, and 8 only. Higher pH could not be used since rare-earth elements might precipitate, as explained before [
29]. Removal or % sorption at pH 7 was 76 ± 0.1% for La, 81 ± 0.3% for Sm, 82 ± 0.3% for Eu, and 76 ± 0.2% for Gd (
Figure 3, and
Table S3). Once the pH was increased, the sorption % also increased due to the lower proton concentration present in the solution (
Table S4). Moreover, it was observed that at higher concentrations of rare-earth elements (1mM), metal adsorption at pH 7 increased to 93% for La, 96% for Sm, 97% for Eu, and 96% for Gd. On the other hand, at pH 7.5 and 8, the sorption increased slightly (
Table S4).
The sorption capacity (
qe in mg/g) at the same pH 7 was 1.7 ± 0.1 mg/g for La, 1.8 ± 0.31 mg/g for Sm, 1.9 ± 0.3 mg/g for Eu, and 1.7 ± 0.3 mg/g for Gd. Once the pH was increased from 7 to 8, the
qe also increased (as shown in
Figure 3 and
Table S5), but no significant changes were observed in the
qe value between 7.5 and 8. Moreover, it was observed that sorption capacities for every rare-earth element analyzed increased 10 orders of magnitude at higher concentrations of rare-earth elements (1mM), as shown in
Table S5. Higher rare-earth element concentrations were tested but growth bacteria were inhibited, and therefore no more experiments were performed.
Sorption isotherms: Equilibrium correlations between sorbent and sorbate are defined by sorption isotherms [
30]. Experimental isotherms were calculated using the Freundlich, Langmuir, and Temkin isotherm models, as represented by Equations (3)–(5), respectively. Calculated isotherm parameters for the sorption of rare-earth elements onto strain SH31 at 30 °C are shown in
Figure 4, and details for other parameters are found in
Tables S5–S7. The best fit was obtained using the Langmuir model, as shown by the highest coefficient value of 1.0. Additionally, the separation factor RL was calculated for every metal, which helps to predict the affinity between the sorbent and sorbate. Every rare-earth element, at different pH values, showed an RL below 1 and higher than 0, which indicates that the shape of the sorption system is favorable [
31,
32]. Considering the Freundlich and Temkin analysis, coefficient values were less than 1 in several elements, which immediately rules out the possibility that these models might fit well for this adsorption process (
Tables S5–S7).
Sorbent characterization by FTIR analysis: Considering that metals are biosorbed by strain SH31, ATR-FTIR analysis was performed to understand the functional groups on the bacterial surface that are involved in metal binding.
Figure 5 shows the FTIR spectra, where important characteristic signals were assigned. Two main bands are observed, at 3300 and 1600 cm
−1 of wavenumbers. When the control sample is compared with the biomass treated with rare-earth elements, changes were detected in both main bands. The first band corresponds to the stretching vibration of OH, and the second band to the stretching C=O bonds. These results might indicate that both functional groups are involved in the sorption of every studied metal.
Bioinformatic analysis: The results of the SH31 strain genome mining resulted in the identification of several genes that have been indirectly related to lanthanide metabolism, resistance, and tolerance (
Table S8). Moreover, the
yfiZ,
yfiY,
yusV, and
feuC genes related to siderophores transport were found in the SH31 genome as well as the
bdlA,
icaR,
ywqC,
pgaB, and
pgaC, which are related with biofilm formation and extracellular polymeric substance production. Also found was a hypothetical protein that has a small similarity to a lanmodulin (C5B164) [
33], which may be evidence of a conserved domain or site.
4. Discussion
The tolerance of strain SH31 to the four rare-earth elements studied showed positive results. This microorganism was able to grow at concentrations of 0.1 and 1 mM for every metal within a pH range of 7 to 8. While there are no reports indicating the pH effect on the growth of these bacteria, the effect of salt concentration on bacterial growth has been previously reported, where this strain was described as halotolerant [
19,
23]. Like the SH31 strain, other microorganisms have also demonstrated tolerance to the accumulation of rare-earth elements. For instance, a study reported that
Thermus scotoductus SA-01 could survive concentrations of up to 1 mM of Eu
3+, reaching OD600 values higher than 1 [
8]. Moreover,
Deinococcus radiodurans could also tolerate concentrations close to 0.25 mM of Eu
3+, making it a potential candidate for the bio-recovery of this valuable element [
9]. In a previous study, the accumulation of rare-earth elements by bacterial isolates from a rare-earth environment was evaluated, revealing a significant accumulation of rare-earth elements, especially Ce and Nd, in
Bacillus cereus [
34]. An additional report explained that Ce could be a potent inhibitor for Gram-negative bacteria and fungi [
35], which might explain why most of the microorganisms described as tolerant to rare-earth elements are Gram-positive. The primary mechanism associated with rare-earth element tolerance is biosorption, as with certain heavy metals. However, the available information on rare-earth element biosorption remains limited. In the context of heavy metal biosorption, various bacteria have undergone scrutiny for their efficacy in bioadsorbing these metals. For instance,
Bacillus licheniformis was noted for its capacity to remove approximately 88% of Cr
6+, while
Bacillus mucilaginosus demonstrated an ability to eliminate about 28% of Fe
3+ and 73% of Pb
2+ [
36].
Examining these reported instances of biosorption, which is a physicochemical and metabolic process, reveals its diverse nature, encompassing absorption, adsorption, ion exchange, surface complexation, and precipitation. This versatile process can also be harnessed for the recovery of rare-earth elements from aqueous solutions [
37]. In the specific case of rare-earth element biosorption, the primary mechanism involves an ion exchange process, primarily engaging the functional groups present on the surfaces of organisms [
37]. In microbial cells, the main functional groups involved in the uptake of rare-earth elements are polysaccharides, glycoproteins, lipids, and others collectively known as extracellular polymeric substances (EPS). The binding sites in these functional groups include carboxyl, amino, sulfhydryl, phosphate, and hydroxyl groups, among others [
23]. For the SH31 strain, it was previously reported to have the capability to produce extracellular polymeric substances [
23]. Under the experimental conditions in this study, it was observed that the SH31 strain is able to produce extracellular polymeric substances both in the absence and presence of rare-earth elements, as indicated by the Congo red assay on plates. Although this assay is not quantitative, a Congo red binding assay was performed for extracellular polymeric substance production using UV–vis spectroscopy. This study demonstrates that the SH31 strain produces extracellular polymeric substances in the absence and presence of metals. This suggests that, in addition to producing extracellular polymeric substances in the presence of 25 g/L NaCl [
23], the bacteria can also produce them in the absence of NaCl. Furthermore, it was observed that
Exiguobacterium sp. SH31 did not show significant changes in the presence of La, Eu, and Gd compared to control samples. This indicates that the SH31 strain continues to produce extracellular polymeric substances in the presence of Eu, La, and Gd, and in the presence of Sm, the production is even increased according to the CR-binding assay. To date, there are no reports showing the production of extracellular polymeric substances by
Exiguobacterium strains in the presence of rare-earth elements.
FTIR spectra of the SH31 strain after rare-earth element sorption showed that hydroxyl and carbonyl groups might be involved in the uptake of these metals. To date, no studies have reported on the biosorption capacity of the SH31 strain for rare-earth elements. However, a previous report demonstrated that
Serratia marcescens can be used to biosorb Y
3+, suggesting the involvement of hydroxyl, amine, and carboxyl groups derived from proteins and polysaccharides in metal biosorption [
38]. Furthermore, the FTIR spectra of a thermophilic bacterium,
Thermus scotoductus SA-01, during the biosorption of Eu
3+, indicated that the interaction occurs mainly through phosphate, carboxyl, and carbonyl of amide groups [
8]. Additionally, another report suggested that carboxyl and phosphate groups might be responsible for the Eu
3+ ion uptake by
Pseudomonas aeruginosa [
39]. Although several studies have considered the uptake of rare-earth elements by microbial cells, the mechanism of the SH31 strain has not been elucidated yet. For instance, the oxidation state of 3+ of rare-earth elements is dominant in the presence of a high concentration of hydroxyl, making rare-earth elements behave as strong acids strongly binding to oxide groups. The rare-earth element hydr(oxy) bonds are expected to have an electrostatic interaction instead of covalent characters such as complexes [
37].
As mentioned before, rare-earth elements are considered strong acids; therefore, ions will preferentially bind to strong bases containing oxygen as the electron-donating atom, like hydroxyl and/or carbonyl groups. Therefore, the shifts in FTIR spectra from the SH31 strain observed might confirm that both functional groups play a role in the interaction with rare-earth elements. More studies will be necessary to define whether the sorption mechanism is an ion-exchange process, as suggested previously [
37].
As described earlier, the sorption capacity of the SH31 strain increased alongside the pH, as a higher pH means lower H
+ concentration, allowing ionic bonds between biosorbents and rare-earth elements [
9]. For instance, the SH31 strain exhibited a higher sorption capacity at pH 8 compared to pH 7. Although the pH difference is not large, functional groups are more protonated at pH 7 than at pH 8. Then, the density of negatively charged molecules increases, leading to higher biosorption capacity. Previously, it was reported that
Bacillus thuringiensis showed a higher biosorption capacity of Eu
3+ at pH 8 compared to acid pH (from pH 2 to 5). The authors suggested that Eu
3+ might be converted into Eu(OH)
2+, Eu(OH)
2+, or Eu(OH)
3 at pH ≥ 6.5, explaining why the maximum biosorption capacity was at pH 8 (160 mg/g), confirming that biosorption is a pH-dependent mechanism [
40]. Also, it was reported that
Pseudomonas sp. (strain MTCC 3087) was able to biosorb lanthanum, and the maximum adsorption capacity was reached at pH 5 (120 mg/g). The main reason is attributable to the deprotonation of functional groups like carboxyl, phosphoryl, and hydroxyl, among others, present in these bacteria [
41].
Thus far, concerning
Exiguobacterium strains, there are no reports showing the sorption capacity of rare-earth elements. Nevertheless, it was reported that the biosorption of non-growing biomass of the ZM-2 strain was approximately 39 mg/g for Cd, 40 mg/g for Ni, 20 mg/g for Cu, and 17 mg/g for Zn. On the other hand, the dried biomass of the ZM-2 strain exhibited a biosorption of approximately 32 mg/g for Cd and Ni, 20 mg/g for Cu, and 15 mg/g for Ni. The optimal pH for the adsorption of Cd, Ni, and Zn was 6.5, while for Cu, it was pH 4.5 [
42]. As mentioned earlier, information on rare-earth element biosorption is extremely limited, especially in
Exiguobacterium strains. However, insights into this process in these bacteria may be obtained from the available information on heavy metal biosorption.
Although higher pH values would lead to increasing negatively charged functional groups and therefore increasing metal biosorption, some elements might precipitate as hydroxide, resulting in low biosorption of the metal. For instance, regarding rare-earth element adsorption of the SH31 strain, similar percentages at pH 7.5 and 8 (over 95%) were observed. Since the optimal pH for growth is 7.5 (
Figure S1), and at pH values higher than 8, rare-earth elements might precipitate [
29], it can be defined that the optimal pH for Sm
3+, Eu
3+, La
3+, and Gd
3+ sorption by the SH31 strain is 7.5.
The sorption capacity of the SH31 strain was observed to be, on average, about 2 mg/g at 0.1 mM of metal and 23 mg/g at 1 mM of metal concentration. Based on these findings, it is recommended that future research incorporates a more extensive range of concentration values, in order to better evaluate the sorption capacity at the equilibrium. Despite this, the initial results offer valuable insights into the sorption capacity of the extremophile under investigation. Furthermore, it is important to note that this study did not explore the selectivity of the SH31 strain for a mixture of multiple metals. Some reports have indicated that
Exiguobacterium sp. exhibits selectivity for certain metals. The authors mentioned that these bacteria demonstrated selective biosorption of Cd and Pb. Therefore, the report suggested that an additional adsorbent should be applied in mixed contaminant solutions [
43].
The maximal metal uptake equilibrium correlation between the SH31 strain and REE
3+ was evaluated by the sorption isotherm over pH values of 7, 7.5, and 8 without NaCl, to avoid the ionic strength effect in the sorption process [
30]. Isotherm curves indicated a desirable affinity of the biosorbent for La, Eu, Sm, and Gd ions. Rare-earth element adsorption by the metal uptake (q) and adsorption capacity using the Langmuir, Freundlich, and Tempkin isotherm models were analyzed. From this work, the Langmuir model fits well for rare-earth element sorption, as the maximum monolayer coverage capacity (qm) was about 1.8 mg/g for 0.1 mM of metal concentration and about 22 mg/g for 1 mM of rare-earth element ions, on average. Kl (Langmuir isotherm constant) ranged from 8 to 46 L/mg, and RL (separation factor) was calculated for every rare-earth element to predict the affinity between cells and metal ions, showing values higher than 0 and lower than 1, indicating favorable biosorption [
6,
42]. Finally, the R
2 value was 1 for every rare-earth element used for sorption studies, confirming that sorption data fitted well to the Langmuir isotherm model. Considering the additional isotherms studied, Freundlich and Temkin, neither fitted well, as mentioned before. The adsorption capacity in Freundlich was lower than 3 mg/g, while for Temkin, it was very similar to the Langmuir isotherm, but the R
2 values were lower than 1. In the case of
Exiguobacterium sp. ZM-2, the maximum capacity (qmax) value by non-growing biomass was 43.5 mg/g for Cd biosorption [
42]. The constant related to the affinity of the metal ion to binding sites (RL) was also found to be below 1 and higher than 0 [
42], like the SH31 strain. An additional study related to lanthanum biosorption by
Pseudomonas sp. showed a qm of 1.926 mg/g, which is similar to the qm of the SH31 strain. In
Pseudomonas sp., the Kl (or b) was 0.0027 L/mg. Both parameters indicate a high affinity and high capacity of La sorption by
Pseudomonas sp. biomass [
41]. The Langmuir and Freundlich isotherms for Europium biosorption by
Bacillus thuringiensis HZM7 were also evaluated previously to understand the adsorption mechanism [
40]. The authors indicated that the Langmuir model is more appropriate for Eu adsorption, considering the R
2 value and the maximal adsorption capacity of 160 mg/g, confirming that
Bacillus thuringiensis HZM7 has a higher adsorbed amount compared to other adsorbents [
40].
Finally, regarding the preliminary genome analysis of the SH31 strain, it was indicated that in this work, it was not possible to find key markers that have been previously associated with rare-earth element resistance, such as xoxF, lanM, xoxJ, xoxG, cox, ctaG, and lammodulins [
44]. Although several siderophore transport-related genes were found in the SH31 strain genome, it is necessary to consider the database limitations regarding these unexplored systems and functions. This limitation may have been the reason for not identifying the markers responsible for the observed phenotypic capabilities in the organism. Further experiments are clearly required to complement these findings.